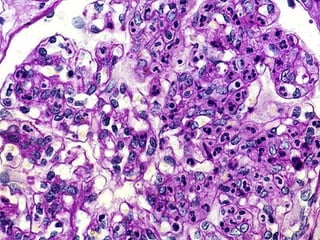

Este documento describe el síndrome nefrítico agudo, incluyendo su definición, etiología, epidemiología, patogenia, manifestaciones clínicas, diagnóstico y tratamiento. El síndrome nefrítico agudo se caracteriza por hematuria, proteinuria y caída aguda de la velocidad de filtración glomerular, y puede ser causado por infecciones, glomerulopatías o enfermedades sistémicas. Los síntomas incluyen edema, hipertensión e insuficiencia renal, y el tratamiento se enfoca en control